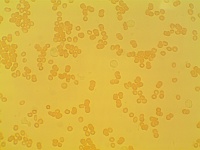

Live Blood Analysis (LBA) is an unique experience that gives the possibility to see with your own eyes the fabric of your body that you are not aware of in everyday life.
Good quality blood parameters will determine the effect and progress of your individual therapy.
How does it work?
We take your blood from the tip of your finger, put it on the microscope slides and we analyse it in the microscope using different magnifications from 100times to 1600times. During the process you can observe your own blood on a computer screen as a digital camera is connected to the microscope.We can take pictures or register short movies with your blood and see its improvement through time.
How to prepare for LBA:
At least for 24 hours prior to LBA you should not drink any alcohol. On the day of the test you shouldn't drink coffee and 2 hours before test you should not eat. At about 1hour before your test, drink minimum 500ml of water with a pinch of natural salt.
Live Blood Analysis shows:
Live Blood Analysis can, among others, suggest:
Fungal infections - candida

Through live blood analysis we can see candida micro spores, individual fungi and fungal colonies.
Acidity in the blood - blood clotting

Acid build up in the body lowers your natural immunity and creates friendly environement for pathogenes to grow and that may show as chronic health problems.
Mineral imbalances
Presence of ortophosphoric acid in the blood indicates calcium deficiency and high acidity build up.
Uric acid

Uric acid is the final step in the breakdown of purines (naturally occurring chemicals that are found in both our diets and our bodies). Uric acid crystals in the blood will indicate metabolic problems. It normally dissolves in the blood, processes through the kidney, and leaves the body in the urine. If the body makes extra uric acid, or if the kidneys cannot clear enough of it, then uric acid levels in the blood will become too high and cause many health issues (kidney stones, joint problems, gout etc.)
Red blood cell damage

Your erythrocytes can be damaged by free radicals or toxic compounds coming from environment or food or from microbiology load in the body (bacteria, fungi, viruses, parasites).
Normally, free radicals, or as they’re also referred to, reactive oxygen species (ROS) and reactive nitrogen species (RNS), live in balance with antioxidants in the body. It is when this balance is disturbed and free radicals multiply that damage is done. The damage done by free radicals in the body is known as oxidation and Oxidative Stress (OS) is believed to lead to the development of disease and disorders.
Heavy metals

Metal toxicity or metal poisoning is the toxic effect of certain metals in certain forms and doses. This applies particularly to cadmium, mercury, lead and arsenic.
Presence of parasitical load in organism

Our body is made of different microorganisms that are supposed to stay in certain balance. If this balance is disrupted it creates a friendly environment for „unwelcomed visitors”.
During the test we can see parasitical larvae protein tissue and toxic damage of red blood cells that can indicate presence of parasites in the body. Live blood analysis is one of the best diagnostic methods for detecting these problems. Symptoms indicating parasitical problems:
cysts, headaches, stomach ache, joints problems, constipation, bloating, allergies, chronic fatigue, overactivity, gnashing of teeth, anemia, skin problems, hair loss, insomnia, low immune system, asthma, being underweight or overweight.
It is very common problem that is reasonably easily addressed by a change in diet and appropriate herbal treatment.



